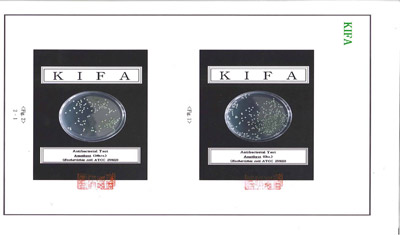
picture of anti bacterial test

|


---------------------------------------------------
Escherichia coli Bacteria Picture put on the Richway Amethyst Biomat after 24 hours (Left side Picture),
Escherichia coli Bacteria Picture before put on the Bio Mat (Right side Picture)

Pseudomonas aeruginosa Bacteria on the Richway Amethyst Biomat after 24 hours (Left side Picture),
Pseudomonas aeruginosa Bacteria before put on the Bio-Mat (Right side Picture)
Reduced Bacteria 60.7%
---------------------------------------------------

---------------------------------------------------

Richway Amethyst Biomat emits 2 different frequencies of Infrared Rays
Richway Amethyst Biomat emits Crystal Infrared Ray
---------------------------------------------------

Richway Amethyst Biomat's Negative Ion EMISSION POWER
---------------------------------------------------

Bio-Mat's EMF (ELECTRO MAGNETIC FIELD) TEST on Richway Amethyst Biomat Professional (BMP)
---------------------------------------------------

Bio-Mat's EMF (ELECTRO MAGNETIC FIELD) TEST on Bio-Mat Mini
---------------------------------------------------

Richway Amethyst Biomat's EMF (ELECTRO MAGNETIC FIELD) TEST on Richway Amethyst Biomat Professional (BMP)
---------------------------------------------------

Richway Amethyst Biomat's EMF (ELECTRO MAGNETIC FIELD) TEST on Richway Amethyst Biomat Mini
*Legal Disclaimer. Information provided is for informational purposes only and is not a substitute for professional medical advice. These studies have not been conducted using the Biomat and are only provided for informational purposes. The Biomat is not approved for any use other than what is stated in the User Manual. Richway and Fuji Bio Inc is neither responsible for nor endorses the contents on this page. Users of the Biomat should not expect results similar to the studies. |
|
Authorized Richway Fuji Bio Inc. Retailer since 2005 Home l Order l Biomat © Copyright 2026 bio-mat.com sales@bio-mat.com ALL RIGHTS RESERVED Site by Navona Designs |